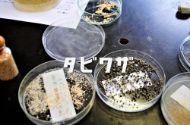
科学館公園

天然温泉 森のゆ





天然温泉 森のゆの割引クーポン・お得チケット情報
この画面を提示しても優待を受ける事は出来ません
各クーポン発行元サイトの画面・会員証提示、事前購入などにより優待を受ける事ができます。-
掲載サイト JAF有効期限 情報なし/不明日帰り温泉入館料 大人50円割引詳細を見る この画面を提示しても優待は受けられません対象者 JAF会員本人、個人会員の同居家族、個人会員と生計を一にする家族利用方法 JAF会員証または会報誌等に掲載のクーポン提示
-
掲載サイト クラブオフ有効期限 情報なし/不明入館料 平日 大人(13歳以上) 50円引詳細を見る この画面を提示しても優待は受けられません対象者 クラブオフアライアンスと提携する各種福利厚生会員が利用可能。BIGLOBEエンジョイプラスなどがその代表。
詳細は【全52社-クラブオフの入会方法まとめ|提携企業・会員になるには】利用方法 各提携サービス会員サイト内のクーポン画面を印刷またはスマホで提示 -
掲載サイト ベネフィットステーション有効期限 2027年3月31日入館料 おとな50円OFF詳細を見る この画面を提示しても優待は受けられません対象者 ベネフィットステーションと提携する各種福利厚生会員が利用可能。Yahoo!のデイリーPlus(デイリープラス)、みんなの優待、駅探バリューDaysなどがその代表。
詳細は【ベネフィットステーション優待を個人契約できるサイトまとめ】利用方法 各提携サービス会員サイト内のクーポン画面を印刷またはスマホで提示
※当サイトでは各企業様が発行するクーポンの紹介のみを行っております。当サイトのいかなる画面を提示しても優待は受けられません。
※当サイトと掲載のある各企業様とは関係がございません。
※クーポンまたは施設情報の最終更新は2026年04月06日です。変更・廃止等の可能性がございますので、事前に最新情報をご確認下さい。
天然温泉 森のゆの施設概要
| 所在地 |
北海道北広島市西の里511番地1 GoogleMapで見る NAVITIMEで見る |
|---|---|
| 電話番号 | 011-375-2850 |
| 公式サイト | 公式サイトを開く |
| 営業時間 | 毎日 9:00~22:00 |
| 定休日 | 年中無休 ※元日休業 |
| アクセス |
JR千歳線 上野幌駅 徒歩8分 札幌南ICより約10分 長沼方面へ約5Km |
| 駐車場 |
有り:200台... |
| 料金 | 通常料金:大人(平日) 700円、(土日祝・特定日) 750円、子供(6歳から12歳) 300円、5歳以下無料、レンタルタオル250円(バスタオルとフェイスタオルのセット) |
掲載内容についてのご指摘はこちら
天然温泉 森のゆ周辺の駐車場
天然温泉 森のゆの周辺には事前に予約できる駐車場があります。
【予約制】akippa セントラルパーキング(北広島市西の里南1-1-12)
目的地まで:約731m / 10分
目的地まで:約731m / 10分
【料金】550円~
最大30%OFFクーポン
【予約制】タイムズのB バロンズコート駐車場
目的地まで:約2.5km / 32分
目的地まで:約2.5km / 32分
【料金】400円
最大10%OFFクーポン
天然温泉 森のゆの周辺には民間駐車場があります。これらは天然温泉 森のゆ公式・提携駐車場では無い場合があり、割引等を受けられない事がありますので事前にご確認下さい。
- タイムズ厚別南 (約2.6km / 33分) 北海道札幌市厚別区厚別南2-11 [地図]
- 新さっぽろアークシティ南駐車場 (約2.8km / 36分) 北海道札幌市厚別区厚別中央2条5丁目493-68 [地図]
- 厚別郵便局サウス駐車場 (約2.9km / 37分) 北海道札幌市厚別区厚別中央二条5丁目1-1厚別郵便局 [地図]
- 厚別郵便局イースト駐車場 (約2.9km / 37分) 北海道札幌市厚別区厚別中央二条5丁目1-1厚別郵便局 [地図]
- 新さっぽろアークシティ東駐車場 (約3.1km / 39分) 北海道札幌市厚別区厚別中央2条5丁目493-64 [地図]
※駐車料金・営業時間等は変更されている場合があります。必ず現地で最新の料金をご確認下さい。